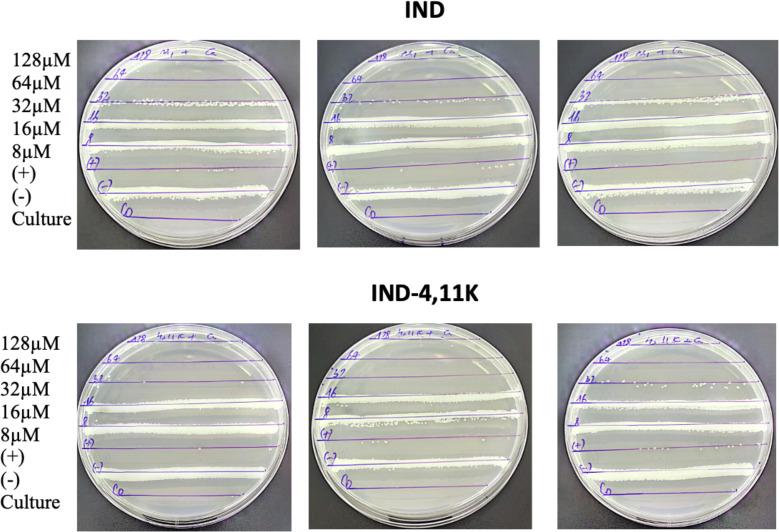
https://cdn.ncbi.nlm.nih.gov/pmc/blobs/96a4/12412968/340d0b3158ee/pone.0331796.g004.jpg

吲哚杀菌素衍生物作为治疗皮肤感染的强效双效抗真菌和抗菌剂:从体外到体内评估的综合研究
Indolicidin derivatives as potent dual-action antifungal and antibacterial agents for the treatment of skin infections: A comprehensive study from in vitro to in vivo evaluation.
作者信息
Ngo Van Hoa, Luong Xuan Huy, Le Viet Hai, Phuong Hai Bui Thi, Do Hai Yen, Thang Nguyen Quoc, Truong Thanh Tung, Yen Thinh Vo, Minh Triet Nguyen, Van Linh Nguyen, Ngo Thu Hang, Can Van Mao
机构信息
Military Hospital 103, Vietnam Military Medical University, Hanoi, Vietnam.
Faculty of Pharmacy, PHENIKAA University, Hanoi, Vietnam.
出版信息
PLoS One. 2025 Sep 5;20(9):e0331796. doi: 10.1371/journal.pone.0331796. eCollection 2025.
As listed by the WHO, the emergence of antibiotic-resistant pathogens, particularly Staphylococcus aureus and Pseudomonas aeruginosa, highlights the urgent need for novel antimicrobial agents. In parallel, fungal infections, especially those caused by Candida albicans, have also become increasingly prevalent and clinically challenging, further emphasizing the necessity for broad-spectrum therapeutic strategies. In particular, skin and soft tissue infections (SSTIs) caused by these bacteria and fungal are common in humans and can lead to severe complications if left untreated. Antimicrobial peptides (AMPs) have gained significant attention due to their broad-spectrum antimicrobial activity and immunomodulatory effects. Indolicidin, a naturally occurring cationic AMP, has demonstrated potent antibacterial and antifungal properties. In this study, we designed and synthesized a novel Indolicidin-derivative peptide IND-4,11K to enhance their antimicrobial activity and stability. The peptide was evaluated in vitro for their antimicrobial efficacy against Gram-positive, Gram-negative bacteria and Candida albicans. IND-4,11K was then prepared in 0-2% cream formula for in vivo testing in rabbit models. These findings suggest that modified Indolicidin-derivatives have potential as novel dual-action antimicrobial agents for treating resistant skin infections and warrant further preclinical investigations.
世界卫生组织列出的抗生素耐药性病原体的出现,尤其是金黄色葡萄球菌和铜绿假单胞菌,凸显了对新型抗菌剂的迫切需求。与此同时,真菌感染,尤其是由白色念珠菌引起的感染,也变得越来越普遍且在临床上具有挑战性,这进一步强调了广谱治疗策略的必要性。特别是,由这些细菌和真菌引起的皮肤和软组织感染(SSTIs)在人类中很常见,如果不治疗可能会导致严重并发症。抗菌肽(AMPs)因其广谱抗菌活性和免疫调节作用而受到广泛关注。吲哚杀菌素是一种天然存在的阳离子抗菌肽,已显示出强大的抗菌和抗真菌特性。在本研究中,我们设计并合成了一种新型吲哚杀菌素衍生肽IND-4,11K,以增强其抗菌活性和稳定性。对该肽进行体外评估,以检测其对革兰氏阳性菌、革兰氏阴性菌和白色念珠菌的抗菌效果。然后将IND-4,11K制成0-2%的乳膏配方,用于兔模型的体内测试。这些发现表明,修饰后的吲哚杀菌素衍生物有潜力作为治疗耐药性皮肤感染的新型双效抗菌剂,值得进一步进行临床前研究。